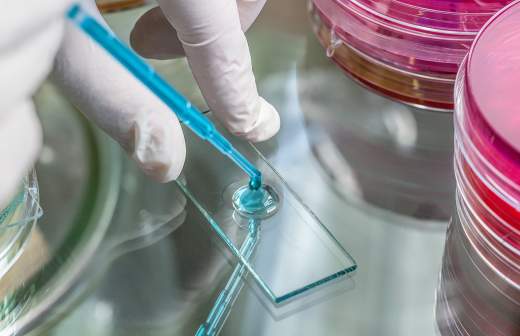

Вспышку неизвестной болезни в Китае связали с рынком морепродуктов

Всемирная организация здравоохранения (ВОЗ) связывает распространение неизвестной болезни в китайском городе Ухань с рынком морепродуктов. Об этом сообщает «РИА Новости» во вторник, 7 января. При этом новой информации о том, что это за болезнь, пока нет.
«Расследование показало, что заболевания могу быть связаны с рыбным рынком, который расположен в Ухани», — сообщила официальный представитель ВОЗ Фадела Чаиб на брифинге в Женеве.
Она добавила, что в ВОЗ пока не поступало новой информации о заболевании с момента запроса данных у китайских властей.
Департамент здравоохранения Гонконга сообщил, что еще девять человек госпитализированы после поездки в Ухань. Всего с 31 декабря 2019 года в специальном административном районе были госпитализированы 30 человек, 13 из них уже выписались.
В ведомстве отметили, что пациенты находятся в стабильном состоянии.
В свою очередь комитет по делам здравоохранения города Ухани уже исключил вероятность атипичной пневмонии (SARS) и ближневосточного респираторного синдрома (MERS).
В конце декабря 2019 власти Китая сообщили о вспышке пневмонии неизвестного происхождения в городе Ухани в китайской провинции Хубэй. В правительстве призвали медицинские учреждения вести статистику и отслеживать ситуацию с больными.